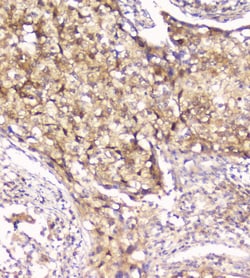
Invitrogen PRDX6 Polyclonal Antibody 100 &mu;g; Unconjugated:Antibodies,

Learn More
Invitrogen™ PRDX6 Polyclonal Antibody


Rabbit Polyclonal Antibody
Brand: Invitrogen™ PA595236
Description
Human Peroxiredoxin 6 shares 90% and 91% amino acid (aa) sequence identity with mouse and rat Peroxiredoxin 6, respectively. Reconstitute with 0.2 mL of distilled water to yield a concentration of 500 μg/mL. Positive Control - WB: human Hela whole cell, human Jurkat whole cell, human MCF-7 whole cell, human 293T whole cell, rat lung tissue, rat liver tissue, mouse lung tissue, mouse liver tissue. IHC: Human Mammary Cancer tissue, human gastric cancer tissue, human Lung cancer tissue, human Ovarian cancer tissue, rat brain tissue. ICC/IF: PC-3 cell. Store at -20°C for one year from date of receipt. After reconstitution, at 4°C for one month. It can also be aliquotted and stored frozen at -20°C for six months. Avoid repeated freeze-thaw cycles.
Peroxiredoxin (Prx) is a growing peroxidase family, whose mammalian members have been known to connect with cell proliferation, differentiation, and apoptosis. Many isoforms (about 50 proteins), collected in accordance to the amino acid sequence homology, containing active site cysteine residue, and the thiol-specific antioxidant activity, distribute throughout all the kingdoms. Among them, mammalian Prx consists of 6 different members grouped into typical 2-Cys, atypical 2-Cys Prx, and 1-Cys Prx. Except Prx VI belonging to 1-Cys Prx subgroup, the other five 2-Cys Prx isotypes have the thioredoxin-dependent peroxidase (TPx) activity utilizing thioredoxin, thioredoxin reductase, and NADPH as a reducing system. Mammalian Prxs are 20-30 kilodalton in molecular size and vary in subcellular localization: Prx I, II, and VI in cytosol, Prx III in mitochondria, Prx IV in ER and secretion, Prx V showing complicated distribution including peroxisome, mitochondria and cytosol.
Specifications
| PRDX6 | |
| Polyclonal | |
| Unconjugated | |
| PRDX6 | |
| 1-Cys; 1-Cys peroxiredoxin; 1-Cys PRX; 1-cysPrx; 24 kDa protein; 9430088D19Rik; AA690119; Acidic calcium-independent phospholipase A2; aiPLA2; Antioxidant protein 2; Aop2; Brp-12; CP-3; epididymis secretory sperm binding protein Li 128m; GPx; HEL-S-128m; KIAA0106; Liver 2D page spot 40; Ltw4; Ltw-4; Lvtw-4; MGC46173; MSP23; NKEFA; Non-selenium glutathione peroxidase; NSGPx; ORF06; p29; PAG; PAGA; PAGB; peroxiredoxin 6; peroxiredoxin-6; Prdx5; Prdx6; PRX; Prx6; Red blood cells page spot 12; thiol-specific antioxidant protein; Tsa | |
| Rabbit | |
| Affinity chromatography | |
| RUO | |
| 11758, 94167, 9588 | |
| -20°C | |
| Lyophilized |
| Immunohistochemistry (Paraffin), Western Blot, Immunocytochemistry | |
| 500 μg/mL | |
| PBS with 5mg BSA and 0.05mg sodium azide | |
| O08709, O35244, P30041 | |
| PRDX6 | |
| E.coli-derived human Peroxiredoxin 6 recombinant protein (Position: E15-P224). | |
| 100 μg | |
| Primary | |
| Human, Mouse, Rat | |
| Antibody | |
| IgG |
Your input is important to us. Please complete this form to provide feedback related to the content on this product.